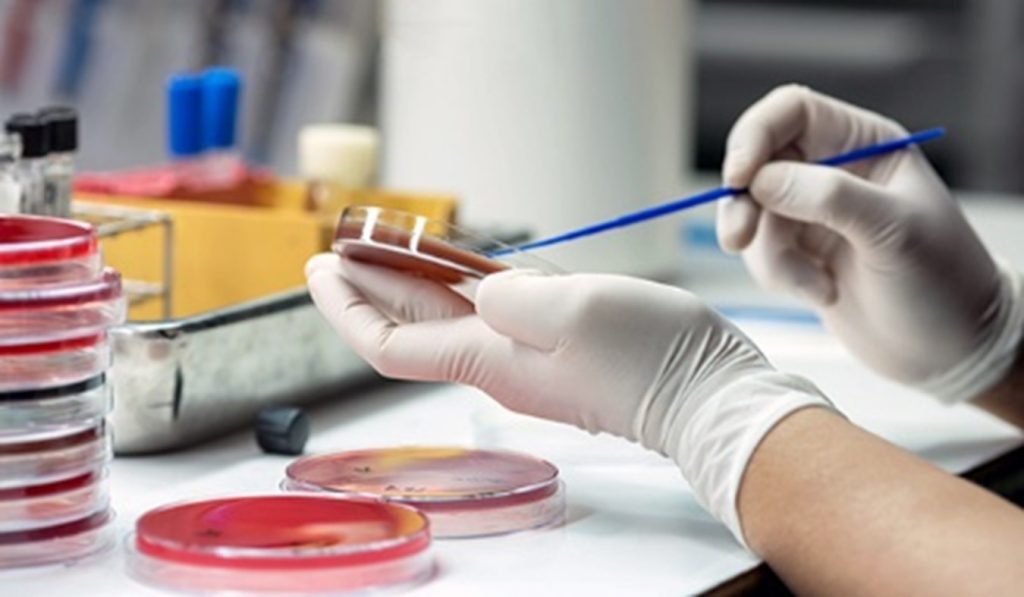

Author: Sarah Daniel

When a natural evolutionary process occurs in a bacterial population, it acts as a powerful, ancient shield that helps safeguard its survival. The development of antibiotic resistance isn’t a deliberate act, but a textbook example of natural selection at work: genetic mutations or acquired resistance genes grant certain bacteria a critical survival advantage when antibiotics are present. Antimicrobial resistance (AMR) is often described as a “silent pandemic”, gradually eroding the effectiveness of our most essential medicines.1 However, we at Ducit Blue Solutions beg to differ, as globally we can’t keep silent about this global health security threat and join collective voices to look at innovations being harnessed globally.
In this fight, a bold new solution is emerging from Kenya: an AI-driven diagnostic innovation developed by a young clinician-programmer that is crossing borders and making waves in France and European wards.1 Dr Mutisya explains that AMR is not limited to bacteria-causing diseases alone; it also arises in parasites such as malaria, fungal infections, and even viruses like HIV, making it a cross-cutting health challenge that demands a One Health approach.1
The Innovation: Antimicro.ai
Dr. Fredrick Mutisya, a physician based at Narok Hospital in Kenya, co-founded Antimicro.ai (with Dr. Rachael Kanguha) as a predictive platform for antibiotic resistance.2
While awaiting lab results, clinicians can use AI to estimate the probability that a given bacterial strain will resist a particular antibiotic, thereby guiding more rational prescription choices (e.g. avoiding broad-spectrum antibiotics when unnecessary).1 The tool leverages large antibacterial surveillance datasets (e.g. Pfizer’s global database containing 850,000+ samples across 83 countries, covering 341 bacterial species and 38 different drugs) as training input, and provides a real-time “AI Model Result” once the user specifies organism, sample type, year, and drug.2

AI in Antimicrobials (Photo: Shutterstock)
Importantly, the team chose an open-source architecture: users can feed in their own institutional or regional data (without that data being stored centrally), enabling localized predictions.2
Because of this flexibility, the platform has seen interest beyond Kenya; including in European clinical settings, where practitioners are exploring whether Antimicro.ai can support decisions in their own wards.1
Why It Matters: Addressing Key Gaps in AMR Response
- Speed and guidance during the “diagnostic gap.” Traditional antimicrobial susceptibility testing can take 24–48 hours or longer. AI-based tools like Antimicro.ai provide real-time decision support, helping reduce inappropriate antibiotic use.6
- Rational antibiotic use and stewardship. Predictive models guide clinicians toward more targeted antibiotic choices, supporting global stewardship goals (World Health Organization.7
- Data-driven surveillance. Aggregated outputs from AI systems can strengthen AMR surveillance networks such as GLASS and inform early warning systems.7
- Bridging diagnostic gaps in LMICs. In settings with limited laboratory infrastructure, AI-assisted prescribing supports informed care while diagnostics expand.2,5
Antibiotic Susceptibility Testing (Image Source: Shutterstock)
Challenges and Risks
No innovation is without obstacles. Some key challenges include:
- Data representativeness & bias. Many global antimicrobial datasets have heavy representation from Europe, North America, and Asia, with far fewer samples from Sub-Saharan Africa. Models trained on such skewed data may underperform in African contexts.2
- Granularity limitations. Pfizer’s dataset, for example, is de-identified at country level. Hospital- or ward-level prediction requires more localised data to refine accuracy.2
- Infrastructure & resource constraints. AI tools require stable power, internet connectivity, compute resources, and technical capacity conditions not consistently present in many low- and middle-income health facilities.5
- Trust, regulatory & ethical concerns. Clinicians must trust the model’s predictions and remain accountable; regulatory frameworks must address liability for misprediction, privacy, and data governance.10
- Sustainability and uptake. Pilots often struggle to scale; integration into routine workflows and securing funding are nontrivial.11
Lessons and Tips for Adoption (for Nigeria & Beyond)
If a similar innovation were to be championed in Nigeria (or other African countries), here are strategic considerations:
- Build local data ecosystems: Hospitals can begin with small institutional datasets such as antibiograms to calibrate predictive models.8
- Partnerships and Stakeholder buy-in: Collaboration between microbiologists, IT experts, and policymakers ensures more relevant adoption.4
- Pilot and validate: Compare AI predictions with lab results to fine-tune performance before scale-up.
- Prioritize usability: Design for low-connectivity environments and train users effectively.
- Develop governance early: Develop or adapt national guidelines/regulations for AI in healthcare; ensuring accountability, privacy, transparency, and equitable access.4
- Promote local innovation: Support research and entrepreneurship in digital health solutions tackling AMR.3
Call to Action
Antimicro.ai is not a silver bullet, but it showcases what is possible when AI, data and clinical insight converge to tackle a major global health threat. The fact that a Kenyan physician-innovator is making inroads into European clinical settings is testament to the universality and ambition of the idea.
For countries like Nigeria, the path is clear: invest in data systems, support homegrown AI health innovators, and create regulatory environments that enable safe deployment. The fight against AMR demands bold thinking and cross-disciplinary collaboration and innovations like Antimicro.ai lights one promising pathway forward.
At Ducit Blue Solutions, we are committed to partnerships that encourage data-driven innovation and context specific solutions towards delivering on the Africa we want in the healthcare sector.
References
- Helen Shikanda. From Kenya to European wards: The AI doctor fighting antimicrobial resistance. (2025) Daily Nation. https://nation.africa/kenya/health/from-kenya-to-european-wards-the-ai-doctor-fighting-antimicrobial-resistance-5214500
- Claudia Lacave. How AI is transforming health care in Kenya amid rapid innovation. VaccinesWork / Gavi. (2024) https://www.gavi.org/vaccineswork/how-ai-transforming-health-care-kenya-amid-rapid-innovation
- World Health Organization. (2025). Global antimicrobial resistance and use surveillance system (GLASS) report: Antibiotic use data for 2022. https://www.who.int/publications/i/item/9789240108127
- World Health Organization; Food and Agriculture Organization of the United Nations; United Nations Environment Programme; World Organisation for Animal Health (WOAH). (2024). Implementing the global action plan on antimicrobial resistance: First quadripartite biennial report. https://www.who.int/publications/i/item/9789240074668
- (2022). Artificial intelligence — the future of antibiotic resistance prevention? ReAct Group. https://www.reactgroup.org/news-and-views/news-and-opinions/year-2022/artificial-intelligence-the-future-of-antibiotic-resistance-prevention/
- Mori, V. (2025). Evaluation of antimicrobial resistance surveillance data sources in clinical practice [Scoping review]. PMC / PubMed Central. https://pmc.ncbi.nlm.nih.gov/articles/PMC11953028/
- World Health Organization. (n.d.). Global Antimicrobial Resistance and Use Surveillance System (GLASS). initiative page. (2025). https://www.who.int/initiatives/glass
- (2023). Embracing a One Health framework to fight antimicrobial resistance (OECD Health Policy Studies). OECD Publishing. https://www.oecd.org/en/publications/embracing-a-one-health-framework-to-fight-antimicrobial-resistance_ce44c755-en.html
- United Nations Environment Programme, Food and Agriculture Organization of the United Nations, World Organisation for Animal Health, & World Health Organization. (2023). Working together to tackle antimicrobial resistance: A One Health response. https://www.who.int/publications/i/item/9789240076266
- World Health Organization. Ethics and governance of artificial intelligence for health: WHO guidance. (2022). https://www.who.int/publications/i/item/9789240029200
- United Nations Environment Programme, Food and Agriculture Organization of the United Nations, World Organisation for Animal Health, & World Health Organization. A One Health priority research agenda for antimicrobial resistance. (2023). https://www.who.int/publications/i/item/9789240075924


